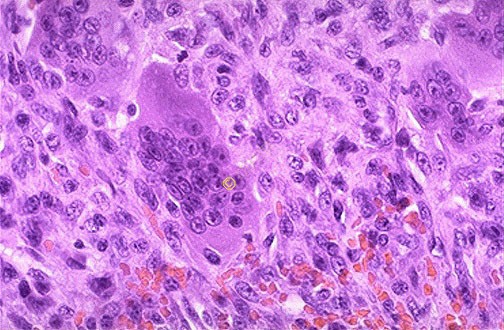

大規(guī)模的短暫轉(zhuǎn)染293F 細胞以快速生產(chǎn)單克隆抗體
材料:
自由式293 培養(yǎng)基, Cat NO 12338
Opti-MEMI, Cat NO 31985
200微克無內(nèi)質(zhì)粒DNA
300 微升 293 Fectin 試劑
轉(zhuǎn)染前一天:
把細胞稀釋到10X106個細胞/毫升, 以確保這些細胞處于對數(shù)生長期。
轉(zhuǎn)染當天:
1. 在37C中預(yù)熱 Opti-MEMI 和自由式293培養(yǎng)基.
2. 用預(yù)熱的自由式293 培養(yǎng)基稀釋細胞到最終容積 300毫升,和細胞密度為1.0X106細胞/ 毫升。 95%以上的細胞必須是活的.
3. 試劑-A的準備: 加200 微克DNA 到10毫升預(yù)熱的Opti=MEMI, 輕輕混合.
4. 試劑-B的準備: 加300 微升 293Fectin 到 10毫升預(yù)熱的Opti-MEMI, 輕輕混合.
5. 室溫下培養(yǎng)不超過 5 分鐘.
6. 5 分鐘后, 把試劑-A 加到試劑-B 里,輕輕混合. 在室溫下培育30 分鐘.
7. 30 分鐘后, 把試劑混合物加到細胞中.
轉(zhuǎn)染后第三天:
加 300毫升預(yù)熱的自由式 293 培養(yǎng)基到燒瓶,最終容量為600 毫升.
轉(zhuǎn)染后第六天:
1. 在 1000 轉(zhuǎn)/分離心細胞 5 分鐘. .收獲過濾的上清液. 把細胞重新懸浮于同體積的預(yù)熱的自由式 293 培養(yǎng)基, 儲存細胞于 4C.
2. 最終容積是 600毫升- 收獲 600毫升上清液.
轉(zhuǎn)染后第十天:
用1000轉(zhuǎn)/分離心細胞 5 分鐘, 收獲過濾的上清液. 從一次轉(zhuǎn)染共收獲1.2 升含抗體的上清液.
注意: 表達水平是以不同的抗體而異, 一般介于50-400 毫克/升的范圍內(nèi).
美中藥源原創(chuàng)文章,轉(zhuǎn)載注明出處并添加超鏈接,商業(yè)用途需經(jīng)書面授權(quán)。★更多深度解析訪問《美中藥源》~
★ 請關(guān)注《美中藥源》微信公眾號 ★

微信號:美中藥源
微信號:美中藥源